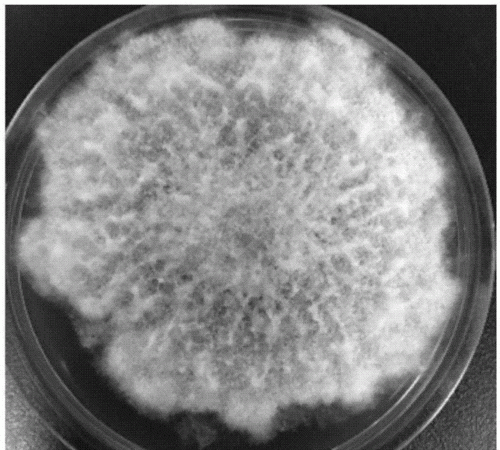
衣服上白色的霉菌是什么
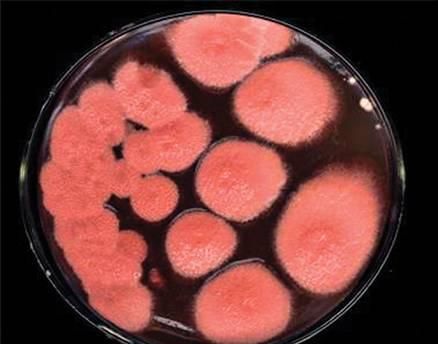
橘子皮上的霉是生物还是非生物污染

霉斑是生物,霉点是由什么组成的说明了什么
霉斑是生物,霉点是由什么组成的说明了什么
本文目录
1.霉点是由什么组成的说明了什么 2.衣服上白色的霉菌是什么 3.橘子皮上的霉是生物还是非生物污染 4.过期的面包上经常会出现一些霉斑这些霉斑是生物吗
霉点是由什么组成的说明了什么
霉菌是由霉菌构成的,霉菌不是细菌,属真菌类。 多通风 用噻菌灵,无味,对人体无害。顺便说一下,用酒精杀霉菌就如同于赶苍蝇一样,杀不死的。这里没了,那里又有了

衣服上白色的霉菌是什么
真核生物 丝状真菌 多为根霉 青霉 毛霉 曲霉
多细胞生物 丝状生长 孢子繁殖为主 有时接合生殖
菌丝有隔或无隔 成体具孢子丝,孢子梗,孢子囊等繁殖结构
橘子皮上的霉是生物还是非生物污染
当然是生物啦.
青霉.!!!!!!!!!!!!!!!!!!!!!!!!!!!!!!!!!!!!!!!!!!!!!!!!!!!!!!!!!!!!!!!!!!!!!!!!!!!!!!!!!!!!!!!!!!!!!!!!!!!!!!!!!!!!!!!!!!!!
过期的面包上经常会出现一些霉斑这些霉斑是生物吗
是霉菌
一般来说是青霉
霉菌的孢子在面包上滋生的
至于为什么.....不知道你问的为什么是生物还是为什么有霉菌
霉菌本来就是生物
至于为什么是霉菌嘛,
1只有霉菌有能产生淀粉水解酶,可以直接利用淀粉
2面包表面的水分活度很低,只有霉菌可以在其表面生长(0.8左右的水分活度)

以上就是关于霉斑是生物 ,霉点是由什么组成的说明了什么的全部内容,以及霉斑是生物吗 的相关内容,希望能够帮到您。
-
- 荔枝晒干可以吃吗,一斤荔枝晒干后有多少?
-
2023-09-22 00:24:35
-
- 黄豆打豆浆要泡多久,豆浆要泡多久?
-
2023-09-21 18:53:34
-
- 防止鞋掉钻小妙招,鞋子上的水钻容易掉怎么办
-
2023-09-21 18:51:30
-
- 2 3尺是多少厘米,2尺3是多少厘米
-
2023-09-21 18:49:24
-
- 小青柑外面一层白色是发霉了吗,小青柑外皮像发霉是什么?
-
2023-09-21 18:47:19
-
- 差强人意什么意思,LED屏幕差强人意是什么意思?
-
2023-09-21 18:45:14
-
- 阳性是什么意思 ,血液为阳性是什么意思?
-
2023-09-21 18:43:09
-
- 下雨后摘桃子是不是不甜,下过雨后的桃子不甜是咋啦
-
2023-09-21 18:41:04
-
- 武鸣区美食,南宁武鸣区有哪些特色美食?
-
2023-09-21 18:38:59
-
- 喜梅名字的寓意,徐红梅名字打分
-
2023-09-21 18:36:54
-
- 身宽是什么和胸围,身幅是指胸围吗
-
2023-09-21 18:34:49
-
- 火车晚上几点熄灯,火车硬座晚上什么时候熄灯
-
2023-09-21 15:58:55
-
- q235b是什么材质,q235b是什么材质的钢材
-
2023-09-21 15:56:50
-
- 速冻饺子冷藏能放几天,速冻饺子可以放多久?
-
2023-09-21 15:54:45
-
- 松茸冷冻后发黄还能吃吗,新鲜松茸冷冻一年还能吃
-
2023-09-21 15:52:40
-
- 台湾的烟肉是什么,什么是高丽菜图片
-
2023-09-21 15:50:35
-
- 韭黄和蒜黄是一样的吗,韭黄和蒜黄哪个贵一点?
-
2023-09-21 15:48:30
-
- 火车几点熄灯,火车卧铺几点熄灯几点开灯
-
2023-09-21 15:46:26
-
- 大寒节气的含义,大寒节气的含义?
-
2023-09-21 15:44:21
-
- 38码内长多少厘米,40码的鞋是多少厘米?
-
2023-09-21 15:42:16



玄幻小说完结巅峰之作排行(2023十大完结巅峰神作)
微量元素有多少种 查微量元素,不要想当然(健康直通车(第67站))